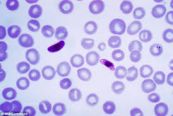
Phết máu dày và mỏng cho bệnh sốt rét: ý nghĩa lâm sàng kết quả xét nghiệm

Cùng với nhu cầu bảo vệ và chăm sóc sức khỏe của con người ngày càng tăng cao, ngành Xét nghiệm y học đang trở thành một trong những ngành học được nhiều thí sinh và phụ huynh quan tâm. Để đáp ứng nhu cầu tham khảo ngày càng nhiều, eLib đã xây dựng danh mục các tài liệu về Xét nghiệm y tế bao gồm điện tâm đồ và bệnh lý, xét nghiệm máu, các thủ thuật xét nghiệm trong chuẩn đoán và điều trị trong lâm sàng... để giúp có thêm kiến thức, kỹ năng về thực hiện kiểm tra, giám sát các quy chế vô khuẩn, quy định về sử dụng hóa chất và sinh phẩm chuyên dụng. Hi vọng sẽ trở thành nguồn tài liệu hữu ích phục vụ cho công tác nghiên cứu, học tập và làm việc của đội ngũ y - bác sĩ.

Có nhiều phương pháp chẩn đoán nhồi máu cơ tim được sử dụng hiện nay, trong đó điện tâm đồ là phương pháp được sử dụng phổ biến nhờ vai trò quan trọng trong việc phân biệt giai đoạn tối cấp, cấp hay đã ổn định của nhồi máu cơ tim. Bài viết này sẽ nói rõ hơn về hội chứng Nhồi máu cơ tim vùng sau dưới tiến triển trên điện tâm đồ. Mời các bạn tham khảo!

Xét nghiệm này được thực hiện để kiểm tra hội chứng Cushing. Đó là một vấn đề trong đó một lượng lớn cortisol được sản xuất bởi tuyến thượng thận. Dưới đây là một số thông tin chi tiết về xét nghiệm này, mời các bạn tham khảo!

Xét nghiệm glycohemoglobin, hay hemoglobin A1c, là xét nghiệm kiểm tra lượng đường (glucose) trong máu liên kết với hemoglobin trong hồng cầu. Cùng eLip tìm hiểu bài viết dưới đây để hiểu rõ hơn về phương pháp xét nghiệm này nhé!

Chụp tủy có thể được thực hiện để tìm khối u, nhiễm trùng, các vấn đề với cột sống như thoát vị đĩa đệm hoặc hẹp ống sống do viêm khớp. Để hiểu rõ hơn về thủ thuật này, mời các bạn tham khảo bài viết dưới đây!

Kiểm tra áp lực bàng quang và Bonney có thể được thực hiện như một phần của kiểm tra thể chất khi tiết ra nước tiểu khi hắt hơi, cười, ho hoặc tập thể dục. Cùng eLip tham khảo bài viết dưới đây để hiểu rõ hơn về thủ thuật này nhé!

Khí máu là một xét nghiệm có giá trị, cung cấp nhiều thông tin cho các bác sỹ, đặc biệt là các bác sỹ làm việc tại các khoa Điều trị Tích cực về tình trạng toan kiềm. Mời các bàn eLib tìm hiểu thêm nhé!

Bức xạ tia bên ngoài cho ung thư tuyến tiền liệt sử dụng chùm tia năng lượng cao được hỗ trợ, chẳng hạn như X-quang để tiêu diệt các tế bào ung thư.Bức xạ tia bên ngoài bệnh ung thư tuyến tiền liệt thường được sử dụng để điều trị ung thư tuyến tiền liệt giai đoạn đầu. Nó cũng có thể được sử dụng cho những người đàn ông có ung thư tuyến tiền liệt tiến triển. Mời các bạn cùng tìm hiểu với Elip nhé!

Các kỳ khám nha khoa thường xuyên giúp bảo vệ sức khỏe răng miệng và sức khỏe chung. Một kỳ khám nha khoa cung cấp cho nha sĩ một cơ hội để cung cấp lời khuyên về việc chăm sóc cho răng và phát hiện bất kỳ vấn đề sớm - khi họ có thể điều trị nhất. Muốn biết thêm về những lợi ích mà việc khám nha khoa mang lại, mời các bạn tham khảo bài viết dưới đây nhé!

Viêm phổi là một trong những bệnh nhiễm trùng cơ hội nghiêm trọng nhất đối với những người nhiễm HIV. Tần suất viêm phổi do Pneumocystis trên người nhiễm HIV ở giai đoạn AIDS là rất cao. Cùng eLip tìm hiểu rõ hơn với những thông tin dưới bài viết nhé!

Xét nghiệm Hormone Inhibin A được thực hiện để đo lượng hormone này trong máu của thai phụ để xem em bé có thể mắc hội chứng Down hay không. Hormone Inhibin A được tạo ra bởi nhau thai trong thai kỳ. Bài viết dưới đây sẽ nói rõ hơn về phương pháp xét nghiệm này, mời các bạn tham khảo!

Bilirubin là một sắc tố vàng da cam, là chất thải của sự vỡ hồng cầu bình thường trong máu, sau đó đi qua gan và cuối cùng ra khỏi cơ thể qua phân (chủ yếu) và một lượng nhỏ có trong nước tiểu. Để hiểu rõ hơn về Bilirubin: ý nghĩa lâm sàng chỉ số xét nghiệm, mời các bạn tham khảo bài viết dưới đây!

Các thủ tục tái định vị canalith có thể di chuyển otoconia một phần mà sẽ không gây chóng mặt. Thực hiện trong phòng của bác sĩ và ở nhà, thủ tục tái định vị canalith bao gồm một số cuộc diễn tập đầu đơn giản. Mời các bạn cùng tìm hiểu thêm nhé!

Tăng kali máu là một bệnh lý hay gặp, lên tới 10% bệnh nhân nội trú. Và một nồng độ kali cao có tỷ lệ tử vong cao nếu không được điều trị kịp thời. Tìm hiểu ngay bài viết dưới đây để hiểu rõ hơn về hội chứng này nhé!

Nhồi máu não chiếm từ 70-80% các trường hợp đột quỵ nhưng có thể chữa khỏi trong khi bệnh nhân bị xuất huyết não dễ tử vong hoặc tàn phế. Để hiểu rõ hơn về bệnh lý này, mời các bạn cùng tham khảo những thông tin dưới đây nhé!

Hệ thống dẫn truyền điện tim được hoạt động như thế nào? Bài viết này sẽ chỉ ra sơ đồ dẫn và cấp máu của hệ thống dẫn truyền điện tim. Mời các bạn tham khảo!

Phân suất co rút mô tả chức năng tâm thu cơ bản của tim. Trong trường hợp không có các bất thường vận động vùng thành tim, điều này có thể đại diện chức năng toàn bộ LV. Tham khảo bài viết ngay dưới đây để hiểu rõ hơn nhé!

Xét nghiệm thẩm thấu huyết thanh được thực hiện trên mẫu máu lấy từ tĩnh mạch. Xét nghiệm này đo lượng các chất hòa tan trong phần huyết thanh của máu. Các chất ảnh hưởng đến thẩm thấu huyết thanh bao gồm natri, clorua, bicarbonate, protein và đường (glucose). Dưới đây là một số thông tin chi tiết về xét nghiệm này, mời các bạn tham khảo!

Xét nghiệm yếu tố thấp khớp được thực hiện để giúp hỗ trợ chẩn đoán viêm khớp dạng thấp. Xét nghiệm này cũng được thực hiện để tìm hiểu xem một đứa trẻ bị viêm khớp tự phát thiếu niên đa khớp có tăng yếu tố thấp khớp hay không. Điều này có thể giúp xác định sự tiến triển của bệnh và cách điều trị tốt nhất cho bệnh. Dưới đây là một số thông tin chi tiết về xét nghiệm này, mời các bạn tham khảo!

Xét nghiệm kháng thể kháng nhân (ANA) đo lượng và mẫu kháng thể trong máu hoạt động chống lại cơ thể (phản ứng tự miễn dịch). Để hiểu rõ hơn về phương pháp xét nghiệm này, mời các bạn tham khảo bài viết dưới đây!
Sốt rét là một căn bệnh rất nghiêm trọng do muỗi đốt và ký sinh trùng nhỏ xâm nhập và nhân lên trong máu. Các triệu chứng có thể bao gồm đau đầu, đau bụng, ớn lạnh, run, sốt và đổ mồ hôi. Bài viết này sẽ nói rõ hơn về Phết máu dày và mỏng cho bệnh sốt rét, mời các bạn tham khảo!